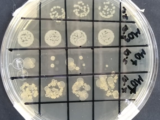

BALANZA COMERCIAL DE MERCANCÍAS DE MÉXICO, MAYO 2021
28 junio, 2021Foto: Internet. El valor de las exportaciones alcanzó 40,798 millones de dólares.
Fuente: INEGI
La información oportuna de comercio exterior de mayo de 2021, indica que se registró un superávit comercial de 340 millones de dólares, saldo que se compara con el déficit de 3,462 millones de dólares obtenido en igual mes de 2020. En los primeros cinco meses de este año, la balanza comercial presentó un superávit de 333 millones de dólares.
EXPORTACIONES
En el quinto mes del año en curso, el valor de las exportaciones de mercancías alcanzó 40,798 millones de dólares, cifra compuesta por 38,526 millones de dólares de exportaciones no petroleras y por 2,272 millones de dólares de petroleras. Así, en el mes de referencia las exportaciones totales mostraron un aumento anual de 125.2%, el cual fue resultado de incrementos de 124.5% en las exportaciones no petroleras y de 137.9% en las petroleras. Al interior de las exportaciones no petroleras, las dirigidas a EU avanzaron a una tasa anual de 124.6% y las canalizadas al resto del mundo lo hicieron en 124 por ciento.
Con series ajustadas por estacionalidad, en mayo de 2021 las exportaciones totales de mercancías reportaron un incremento mensual de 1.20%, el cual fue resultado de la combinación de un aumento de 1.31% en las exportaciones no petroleras y de una caída de 0.72% en las petroleras.
IMPORTACIONES
En mayo de 2021, el valor de las importaciones de mercancías fue de 40,459 millones de dólares, monto que implicó un aumento anual de 87.5 por ciento. Dicha cifra fue reflejo de crecimientos de 80.8% en las importaciones no petroleras y de 184.1% en las petroleras. Al considerar las importaciones por tipo de bien, se observaron ascensos anuales de 116% en las importaciones de bienes de consumo, de 89.4% en las de bienes de uso intermedio y de 43% en las de bienes de capital.
Con series ajustadas por estacionalidad, las importaciones totales mostraron un crecimiento mensual de 4.22%, que se derivó de alzas de 2.64% en las importaciones no petroleras y de 19.93% en las petroleras. Por tipo de bien, se presentaron avances mensuales de 16.65% en las importaciones de bienes de consumo, de 2.50% en las de bienes de uso intermedio y de 3.06% en las de bienes de capital.
Información completa en inegi.org.mx